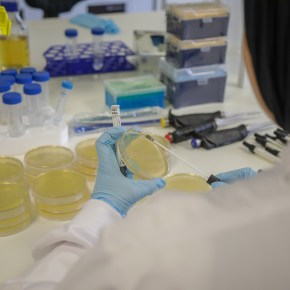
The straw that might break the camel’s back: exploring the link between COVID-19 and antibiotic resistance in low- and middle-income&nbsp;countries

This post was written by Murat Sartas and Saba Ermyas, and edited by Paul Karaimu. The International Livestock Research Institute (ILRI) Impact at Scale (I@S) program recently share examples for identifying, analysing and integrating scaling tools into agricultural research for development programs. At an October 2020 scaling webinar for the science leaders community, which was co-organised by GIZ Task Force on Scaling and CGIAR Science … Continue reading
Category Archives: Research
‘To turn the unknown into the known’: Inside the global effort to bring the fight to viruses
Dennis Carroll, chair of the Global Virome Project Leadership Board, an ambitious global effort to develop a comprehensive database of viruses and detect and track down the planet’s unknown and emerging viral threats, spoke with Jimmy Smith, the International Livestock Research Institute’s (ILRI) director general, at the institute’s weekly virtual meeting on 18 Nov 2020. … Continue reading
Building gender sensitivity into the next generation of livestock scientists
About 20 research and graduate fellows attended a virtual training entitled ‘Integrating gender into livestock research’ which took place 16–17 Jul 2020. This two-day course was facilitated by Zoë Campbell and Renee Bullock of ILRI and hosted by Wellington Ekaya, ILRI’s head of capacity development. Continue reading
New project to improve agricultural productivity in Zimbabwe
A new European Union-funded ‘Livestock Production Systems in Zimbabwe’ (LIPS-Zim) project is working to increase agricultural productivity in the country’s agro-ecological Zones IV and V. It is promoting the adoption of climate-relevant innovations in livestock production systems and improving surveillance and control of livestock diseases. Launched on 1 January 2020, the LIPS-Zim project is implemented … Continue reading
The good and not-so-good news about the state of COVID-19 vaccine development: A primer from ILRI
Jimmy Smith, director general of the International Livestock Research Institute (ILRI), holds a weekly town hall for the 600-plus staff of the institute as well as staff from many of ILRI partners who are hosted on ILRI campuses in Nairobi, Addis Ababa and elsewhere. In the town hall last week, Vish Nene, co-leader of ILRI’s Animal and Human Health program, made a short presentation on the latest developments in COVID-19 vaccine work. Excerpts and slides from his virtual presentation follow. Continue reading
ILRI’s scientists receive the African Academy of Science and Royal Society FLAIR Fellowship
ILRI scientists Lillian Wambua and Abel Gari have received the Future Leaders – African Independent Research (FLAIR) fellowship award. Continue reading
The straw that might break the camel’s back: exploring the link between COVID-19 and antibiotic resistance in low- and middle-income countries
Antibiotics play a pivotal role in a pandemic both as prophylaxis – to prevent bacterial infections – as well as pre-emptive treatment. The emergence and rapid spread of COVID-19 highlights the importance of diagnostic testing, which is also important for antibiotic resistance and successful treatment outcomes Continue reading
ILRI’s response to the pandemic: A deepening engagement with the press and policymakers
ILRI is launching an initiative to share, as broadly as possible, its research on issues related to COVID-19 with the media, policymakers and the public, and to make its experts available to comment on fast-moving developments in the field. Continue reading
ILRI computing capacity made available to COVID-19 vaccine developers
While the ILRI campuses in Nairobi and Addis Ababa are uncharacteristically empty, the institute’s servers are working away at top speed, contributing to the first essential steps in developing a vaccine against COVID-19. Continue reading
ILRI adopts new framework for scaling up livestock research for development
ILRI’s Impact at Scale program reviewed the landscape of scaling with the aim of summarizing relevant approaches and tools that livestock projects can benefit from. The resulting ILRI framework provides an overview of the steps along with short summaries and assessments of nine tools related to scalability assessment. Continue reading